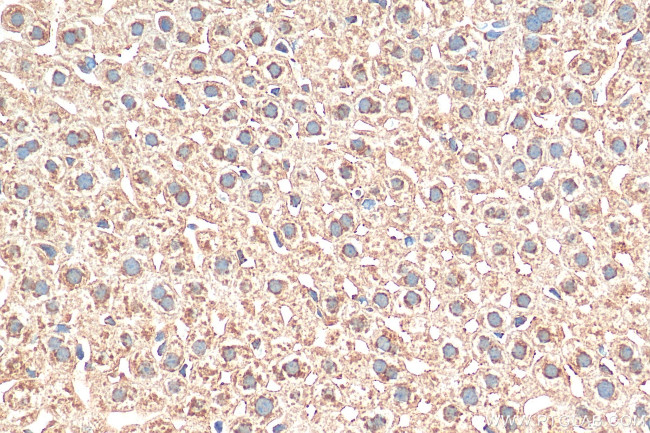
EBPL Antibody in Immunohistochemistry (Paraffin) (IHC (P))

Search
Proteintech
EBPL Polyclonal Antibody
{{$productOrderCtrl.translations['antibody.pdp.commerceCard.promotion.promotions']}}
{{$productOrderCtrl.translations['antibody.pdp.commerceCard.promotion.viewpromo']}}
{{$productOrderCtrl.translations['antibody.pdp.commerceCard.promotion.promocode']}}: {{promo.promoCode}} {{promo.promoTitle}} {{promo.promoDescription}}. {{$productOrderCtrl.translations['antibody.pdp.commerceCard.promotion.learnmore']}}
产品信息
17904-1-AP
种属反应
宿主/亚型
分类
类型
抗原
偶联物
形式
浓度
规格
纯化类型
保存液
内含物
保存条件
运输条件
产品详细信息
Immunogen sequence: GLHLGRGQGA ADRGALIWLC YDALVHFALE GPFVYLSLVG NVANSDGLIA SLWKEYGKAD ARWVYFDPTI VSVEILTVAL DGSLALFLIY AIVKEKYYRH FLQITLCVCE LYGCWMTFLP EWLTRSPNLN TSNWLYCWLY LFFFNGVWVL IPGLLLWQSW LELKKMHQKE TSSVKKFQ
靶标信息
EBPL does not possess sterol isomerase activity and does not bind sigma ligands.
仅用于科研。不用于诊断过程。未经明确授权不得转售。
篇参考文献 (0)
生物信息学
蛋白别名: emopamil binding protein like; emopamil binding related protein, delta8-delta7 sterol isomerase related protein; Emopamil-binding protein-like; Emopamil-binding-related protein
基因别名: 5730442K12Rik; EBPL; EBRP; ERP
UniProt ID: (Human) Q9BY08, (Mouse) Q9D0P0
Entrez Gene ID: (Human) 84650, (Rat) 361054, (Mouse) 68177